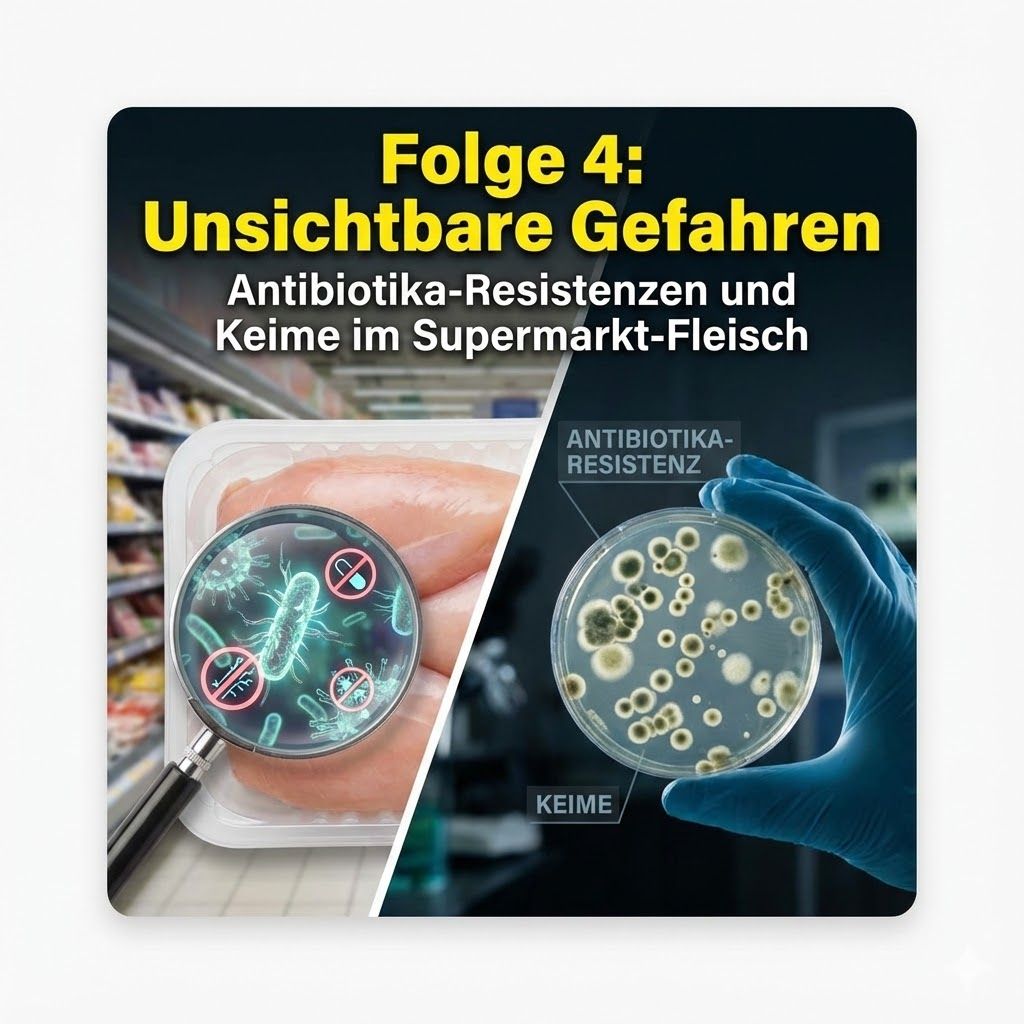
Unsichtbare Gefahren – Antibiotika-Resistenzen und Keime im Supermarkt-Fleisch (Folge 04)

Willkommen bei „Waldesruh Ernährungspfad“, dem Podcast für alle, die sich bewusst und ganzheitlich mit ihrer Ernährung auseinandersetzen möchten. 🌿✨ Als erfahrener Ernährungsberater und Fitnesscoach begleite ich Sie auf Ihrem individuellen Weg zu mehr Wohlbefinden, Energie und Vitalität. Äußerungen unserer Gesprächspartner*innen und Moderator*innen geben deren eigene Auffassungen wieder. https://meinpodcast.de macht sich Äußerungen seiner Gesprächspartner*innen in Interviews und Diskussionen nicht zu eigen.
Alle Folgen
Unsichtbare Gefahren – Antibiotika-Resistenzen und Keime im Supermarkt-Fleisch (Folge 04)
Ich begrüße Sie zu einer sehr ernsten Episode. Wir sprechen über das, was Sie auf dem Etikett im Supermarkt nicht sehen: Multiresistente Keime. Durch den massiven Einsatz von Antibiotika in der Tiermast – oft auch an gesunde Tiere im Rahmen der sogenannten Metaphylaxe – züchten wir gefährliche Erreger wie MRSA und ESBL heran. Wir analysieren, warum gerade Puten- und Hähnchenfleisch, das oft als gesunde, magere Alternative gilt, häufig mit diesen Keimen belastet ist. Zudem thematisieren wir die Gefahr durch Campylobacter und Salmonellen und warum die industrielle "Tierproduktion" der ideale Nährboden für die nächste Gesundheitskrise ist.Produktempfehlung der Woche: In Zeiten hoher Belastung ist ein starkes Immunsystem Ihre wichtigste Verteidigungslinie. Nutzen Sie natürliches Vitamin C zur Stärkung Ihrer Abwehrkräfte. 👉 Bio Hagebuttenpulver von Waldkraft: https://www.waldkraft.bio/bio-hagebuttenpulver?sPartner=weiszpflog Weiterführende Links: Hier finden Sie alle Quellen im Buch: https://amzn.to/4i4y5LO Werden Sie Teil unserer Community auf YouTube: https://www.youtube.com/@Waldesruh-Begleitung/ Supporten Sie uns: "Ein Beitrag für unabhängige Aufklärung." https://steady.page/de/waldesruh/posts Waldesruh – Gemeinsam durch die Jahreszeiten des Lebens.Dieser Podcast wird vermarktet von der Podcastbude.www.podcastbu.de - Full-Service-Podcast-Agentur - Konzeption, Produktion, Vermarktung, Distribution und Hosting.Du möchtest deinen Podcast auch kostenlos hosten und damit Geld verdienen?Dann schaue auf www.kostenlos-hosten.de und informiere dich.Dort erhältst du alle Informationen zu unseren kostenlosen Podcast-Hosting-Angeboten. kostenlos-hosten.de ist ein Produkt der Podcastbude. (00:00) Einleitung (00:47) Ein tragisches Fallbeispiel: Die Rücken-OP von Matthias Wolfs Mutter (01:58) Faktorenkrankheit: Warum das System Stall die Tiere krank macht (02:53) Metaphylaxe: Massenmedikation statt Einzeltherapie (03:52) Die NRW-Studie: 100% Antibiotika-Einsatz bei Mastkälbern (04:43) Selektionsdruck: Das "Trainingslager" für Superkeime (05:23) Übertragungswege: Von der Abluft bis zur Kühltheke (06:37) MRSA: Der Keim, der vom Tier auf den Menschen springt (07:37) ESBL: Wie Enzyme unsere "Medizin-Schlüssel" zerbrechen (08:46) Campylobacter & Guillain-Barré: Tödliche Gefahr im Geflügel (09:58) Prognose 2050: Das Ende des Antibiotika-Zeitalters? (11:14) Die Straßenbahn-Metapher: Wie Bakterien Resistenzen austauschen (12:04) Fazit: Der perverse Tauschhandel – Billigfleisch gegen Gesundheit
Der Milch-Mythos – Industrieprodukt statt Naturtrunk (Folge 03)
Guten Tag. "Die Milch macht's" – so lautete einst der Slogan. Doch was macht die moderne Industriemilch eigentlich mit uns? In dieser Folge dekonstruieren wir den Mythos der gesunden Milch. Wir diskutieren, wie Homogenisierung und Ultrahocherhitzung (H-Milch) das einstige Naturprodukt zu einer, wie Hans-Ulrich Grimm es nennt, "Totmilch" verändern. Ein kritischer Blick gilt dem Wachstumsfaktor IGF-1, der im Verdacht steht, Tumorwachstum zu begünstigen , sowie dem Unterschied zwischen herkömmlichem A1-Kasein und dem verträglicheren A2-Kasein. Wir beleuchten, warum selbst Kalzium in der Milch nicht zwangsläufig vor Knochenbrüchen schützt und welche pflanzlichen Alternativen Ihren Körper weniger belasten. Produktempfehlung der Woche: Ein gesundes Mikrobiom ist essenziell, um Nahrungsmittelunverträglichkeiten entgegenzuwirken. Unterstützen Sie Ihren Darm mit der Kraft des Moores. 👉 Moor-Liquid von Waldkraft: https://www.waldkraft.bio/moor-liquid?sPartner=weiszpflog Weiterführende Links: Das Buch "Die Fleischlüge": https://amzn.to/4i4y5LO Unser Kanal für bewusste Lebensweise: https://www.youtube.com/@Waldesruh-Begleitung/ Helfen Sie uns zu wachsen: "Waldesruh braucht Wurzeln." https://steady.page/de/waldesruh/posts Waldesruh – Gemeinsam durch die Jahreszeiten des Lebens.Dieser Podcast wird vermarktet von der Podcastbude.www.podcastbu.de - Full-Service-Podcast-Agentur - Konzeption, Produktion, Vermarktung, Distribution und Hosting.Du möchtest deinen Podcast auch kostenlos hosten und damit Geld verdienen?Dann schaue auf www.kostenlos-hosten.de und informiere dich.Dort erhältst du alle Informationen zu unseren kostenlosen Podcast-Hosting-Angeboten. kostenlos-hosten.de ist ein Produkt der Podcastbude. (00:00) Einleitung: Moderne Milch versus Ur-Typ (01:13) Die traditionelle Kuh: Hörner als Sinnesorgan (02:30) Die Hochleistungskuh: Stress und Kraftfutter (03:53) Veränderte Proteine: A1-Casein und BCM 7 (05:12) Wachstumsfaktoren und Hormone (06:16) Homogenisierung: Mechanische Zerkleinerung (07:16) Ultrahocherhitzung: Die "tote" H-Milch (08:24) Gesundheitsfolgen: Knochen-Mythos und Studien (10:01) Der Gegenentwurf: Rohmilch und vollfette Produkte (11:05) Reaktion der Industrie und Fazit

Wurst, Schwein & Co. – Die Entzündungsfalle (Folge 02)
Herzlich willkommen zu einer weiteren vertiefenden Episode. Heute liegt unser Fokus auf dem roten Fleisch und verarbeiteten Produkten wie Wurst. Die Weltgesundheitsorganisation (WHO) hat verarbeitetes Fleisch als krebserregend eingestuft – ein Warnsignal, das wir ernst nehmen müssen. Wir untersuchen die Rolle der Arachidonsäure, die besonders reichhaltig in Schweinefleisch vorkommt und im menschlichen Körper entzündliche Prozesse wie Rheuma, Arthritis und Gicht befeuern kann. Zudem werfen wir einen Blick auf die stressbedingten Belastungen der Tiere in der industriellen Haltung, die sich letztlich in der Qualität des Fleisches niederschlagen. Erfahren Sie, warum weniger hier definitiv mehr für Ihre Gesundheit bedeutet. Produktempfehlung der Woche: Leiden Sie unter Gelenkthemen oder möchten Sie Entzündungen vorbeugen? Die Natur bietet hier kraftvolle Unterstützung für den Bewegungsapparat. 👉 Arthridea von Waldkraft. Weiterführende Links: Vertiefende Lektüre: Abonnieren Sie unseren YouTube-Kanal: Gefällt Ihnen unser Podcast? "Schenken Sie uns Energie für die nächste Recherche." Waldesruh – Gemeinsam durch die Jahreszeiten des Lebens.Dieser Podcast wird vermarktet von der Podcastbude.www.podcastbu.de - Full-Service-Podcast-Agentur - Konzeption, Produktion, Vermarktung, Distribution und Hosting.Du möchtest deinen Podcast auch kostenlos hosten und damit Geld verdienen?Dann schaue auf www.kostenlos-hosten.de und informiere dich.Dort erhältst du alle Informationen zu unseren kostenlosen Podcast-Hosting-Angeboten. kostenlos-hosten.de ist ein Produkt der Podcastbude. (00:00) Einführung & Die Kernfrage: Vorstellung des Themas "Warnungen vor Wurst" und Einführung des Buches »Die Fleischlüge« von Hans-Ulrich Grimm. Unterscheidung zwischen traditionellem Metzgerhandwerk und industrieller Massenware. (01:17) Der WHO-Paukenschlag: Die Einstufung von verarbeitetem Fleisch in die höchste Krebserregungs-Kategorie (Gruppe 1) durch die Weltgesundheitsorganisation, vergleichbar mit Asbest und Tabak. Erklärung, dass dies die Sicherheit der Beweislage betrifft, nicht die direkte Gefährlichkeit. (02:22) Sterberisiko & "Die Zigarette der Zukunft": Diskussion über das Zitat, Wurst sei die "Zigarette der Zukunft". Daten der Harvard School of Public Health: 50g verarbeitetes Fleisch täglich erhöhen das Sterberisiko um 20%. (03:53) Herz, Hirn & Fruchtbarkeit: Spezifische Risiken jenseits von Krebs: Herzinfarkt, Schlaganfall und das Beispiel des "Bacon-Sandwich", das theoretisch das Leben verkürzt. Erwähnung sinkender Samenqualität und Fruchtbarkeit durch Wurstkonsum. (05:04) Diabetes & Entzündungen: Der Zusammenhang zwischen Nitritpökelsalz und Diabetes Typ 2. Die Rolle der Arachidonsäure in Schweinefleisch als "Brandbeschleuniger" für Entzündungen wie Gicht und Arthritis. (06:32) Das Fallbeispiel Emilia: Eine persönliche Anekdote über Schmerzschübe nach Schweinefleischkonsum, um die statistischen Risiken greifbar zu machen. (07:06) Das industrielle Schweinesystem: Die Kritik an der Massentierhaltung, Fütterung und Medikamenteneinsatz als Ursache für mindere Fleischqualität. (07:53) Der Chemie-Baukasten (Glutamat & Phosphate): Analyse der Zusatzstoffe. Glutamat als umstrittenes "Nervenzellgift" und Phosphate, die Arterien und Knochen schaden können. (09:11) Nitritpökelsalz & E-Nummern-Cocktails: Die Risiken von Nitriten (Nitrosamin-Bildung). Das Beispiel der endlosen Zutatenliste eines Bordbistro-Sandwiches der Deutschen Bahn. (11:09) Fazit & Alternativen: Zusammenfassung der Kritik am industriellen System ("Verlust der Unschuld" des Lebensmittels). Ausblick auf Alternativen wie Weidefleisch und die Frage nach einer Systemänderung.

Die Fleischlüge – Das Kernproblem der industriellen Tiermast (Folge 01)
Guten Tag, geschätzte Damen und Herren. In unserer Auftaktfolge widmen wir uns einer unbequemen Wahrheit, die der Autor Hans-Ulrich Grimm in seinem Werk "Die Fleischlüge" minutiös aufdeckt. Wir analysieren, wie die moderne Massentierhaltung nicht nur Tierleid verursacht, sondern direkte, negative Auswirkungen auf die menschliche Physiologie hat. Wir besprechen den Fall von Irene Huber, deren gesundheitlicher Verfall exemplarisch für die Folgen einer unreflektierten Fleisch-Überdosis steht. Zudem beleuchten wir biochemische Prozesse: Wussten Sie, dass der übermäßige Konsum tierischer Proteine den Insulinspiegel ähnlich stark ansteigen lassen kann wie Zucker? Wir klären auf, warum das Steak zum Salat nicht immer die gesündeste Wahl ist und wie die "Proteinmast" Zivilisationskrankheiten begünstigt. Produktempfehlung der Woche: Um Ihre Leber bei der Entgiftung und dem Stoffwechsel zu unterstützen – gerade wenn Sie Ihre Ernährung umstellen – empfehle ich Ihnen die Kraft der Mariendistel. 👉 Mariendistel Samen (gemahlen) von Waldkraft. Nutzen Sie meinen Code: weiszpflog, um einen Rabatt von 10 % zu erhalten. Weiterführende Links: Das Buch zur Sendung. Besuchen Sie uns auf YouTube für visuelle Inhalte. Unterstützen Sie unsere Recherchearbeit: "Ein Kaffee für die Wissenschaft." Waldesruh – Gemeinsam durch die Jahreszeiten des Lebens.Dieser Podcast wird vermarktet von der Podcastbude.www.podcastbu.de - Full-Service-Podcast-Agentur - Konzeption, Produktion, Vermarktung, Distribution und Hosting.Du möchtest deinen Podcast auch kostenlos hosten und damit Geld verdienen?Dann schaue auf www.kostenlos-hosten.de und informiere dich.Dort erhältst du alle Informationen zu unseren kostenlosen Podcast-Hosting-Angeboten. kostenlos-hosten.de ist ein Produkt der Podcastbude. (00:00) Einleitung: Zivilisationskrankheiten & Fleisch: Die provokante These, dass Diabetes, Herzinfarkt und Rheuma direkte Folgen der industriellen Tierhaltung sind. (00:36) Die Masse macht's: Preiskampf & Überkonsum: Wie Dumpingpreise (z. B. 2,22 Euro für Schweinenacken) den Konsum von Schweinefleisch um 80 % haben ansteigen lassen. (01:58) Der Diabetes-Mythos & "Proteinmast": Warum nicht nur Zucker, sondern auch tierisches Protein zu Blutzucker umgewandelt wird und das Diabetesrisiko um 118 % erhöhen kann – ein Widerspruch zum Low-Carb-Trend. (03:53) Entzündungen & Arachidonsäure: Die veränderte Biochemie der "Labortiere". Das Beispiel Emilia und wie Arachidonsäure im Schweinefleisch Schmerzschübe und Entzündungen (Rheuma, Arthritis) befeuert. (06:10) Die Milch-Problematik (Hormone & Enzyme): Risiken durch Wachstumshormone (EGF-1) in Milch von trächtigen Kühen und Gefäßschäden durch Homogenisierung (Xanthin-Oxidase). (08:54) Unsichtbare Gefahren im Stall: "Faktorenkrankheiten" durch extreme Enge (26 Hühner/qm). Die Verbindung von Campylobacter-Keimen zu Lähmungserscheinungen (Guillain-Barré-Syndrom). (10:43) Die Antibiotika-Krise: Der prophylaktische Einsatz von Medikamenten führt zu multiresistenten Keimen (MRSA). Das tragische Fallbeispiel vom Tod der Mutter von Matthias Wolf. (12:23) Fazit & Systemkritik: Zusammenfassung der drei Risikofaktoren (Menge, Qualität, Keime) und die abschließende Frage nach Alternativen wie Weidehaltung oder Verzicht.

Natron – Das universelle Pulver für Haushalt und Wohlbefinden
Natron (Natriumhydrogencarbonat, NaHCO₃) ist ein natürlich vorkommendes Salz. Es ist auch unter den Handelsnamen Kaiser Natron oder Bullrich-Salz bekannt. Es ist wichtig, es nicht mit Natriumcarbonat (Waschsoda) oder Natriumhydroxid (Ätznatron) zu verwechseln. Seine primäre Eigenschaft ist seine Alkalität (Basizität). Es reagiert mit Säuren unter Freisetzung von Wasser und Kohlendioxid (CO₂). Diese einfache chemische Reaktion ist der Schlüssel zu fast all seinen Anwendungen. Basicum - Natron Sango-Koralle von Waldkraft: 🛒 https://www.waldkraft.bio/basicum-natron-sango-koralle-120-dr-kapseln ⸻ 🏬 Amazon Die beste Auswahl für Natron 🛒 https://amzn.to/4nv99hL ⸻ 🌿 Waldkraft Die Kraft der Natur für Mensch & Tier Erleben Sie hochwertige Naturprodukte – von kolloidalem Silber bis Vitalpilzen. 💚 Jetzt 10 % Rabatt sichern mit dem Code: weiszpflog 👉 Direkt zum Shop 🛒 http://tinyurl.com/Waldkraft ⸻ 🎥 maona.tv Über 1.000 Filme, Vorträge & Interviews für Bewusstsein & Wandel Erleben Sie Wissen, das inspiriert. 🎬 Jetzt 14 Tage kostenlos testen 👉 Hier starten 🛒 https://tinyurl.com/tvmaona ⸻ 🎵 Gratis Meditationsalbum „Source Code“ inkl. neowake® 7 Tage Testphase Erleben Sie Klangfrequenzen für Balance & Klarheit. 👉 Jetzt sichern 🛒 https://tinyurl.com/f3yfczpp ⸻ 🔍 Metanoia Magazin Die investigative Themen-Zeitung aus der Schweiz Tauchen Sie ein in unabhängigen Journalismus, der Fragen stellt, wo andere schweigen. 👉 Jetzt entdecken 🛒 https://tinyurl.com/metanoia-magazin ⸻ 💬 Falls es Fragen gibt, beantworte ich die gerne in den Kommentaren oder auf den üblichen Kanälen: E-Mail: waldesruh@mailbox.org Webseite: https://sites.google.com/view/waldesruh-begleitung/startseite WhatsApp: https://wa.me/message/2SKXRLW4CQDHN1 Instagram: https://www.instagram.com/waldesruhbegleitung/ 🔎 Transparenzhinweis: Die mit „🛒“ oder entsprechenden Verweisen gekennzeichneten Links sind Affiliate-Links. Das bedeutet: Wenn Sie über einen dieser Links einkaufen, erhalte ich eine kleine Provision – ohne Mehrkosten für Sie. So unterstützen Sie meine Arbeit – z. B. den Waldesruh Ernährungspfad Podcast, Recherchen und neue Inhalte rund um gesunde Ernährung & ganzheitliches Leben. 💚 Vielen Dank für Ihre Unterstützung!Dieser Podcast wird vermarktet von der Podcastbude.www.podcastbu.de - Full-Service-Podcast-Agentur - Konzeption, Produktion, Vermarktung, Distribution und Hosting.Du möchtest deinen Podcast auch kostenlos hosten und damit Geld verdienen?Dann schaue auf www.kostenlos-hosten.de und informiere dich.Dort erhältst du alle Informationen zu unseren kostenlosen Podcast-Hosting-Angeboten. kostenlos-hosten.de ist ein Produkt der Podcastbude. (00:00) Einleitung: Natron als unterschätzte Alternative? (00:56) Position 1: Das Plädoyer für Natron (01:13) Position 2: Die kritische Distanz und Warnungen (01:36) Pro: Kritik an Industrieprodukten (Aluminium, Mikroplastik) (03:01) Kontra: Die Gefahr der Verwechslung (Ätznatron) und Alkalose (04:39) Pro: Detaillierte Gesundheits-Potenziale (Milz-Studie, Nieren) (06:22) Kontra: Mangelnde Evidenz und Warnungen vor Selbstbehandlung (08:18) Pro: Natron als Alleskönner im Haushalt (DIY-Rezepte) (09:57) Kontra: Grenzen im Haushalt (Herstellung, Kalk, Materialverträglichkeit) (11:34) Schlussplädoyer Pro: Natron als Symbol der Rückbesinnung (12:39) Schlussplädoyer Kontra: Nützlich, aber limitiert und mit Risiken (14:06) Zusammenfassung: Eine komplexe Bewertung

Moor-Elixier – Das schwarze Gold für Darm und Entgiftung
Ein Moor-Elixier ist kein Schlamm, sondern ein hochkonzentrierter, flüssiger Extrakt aus speziellem Heilmoor. Dieses Moor ist das Endprodukt eines jahrtausendelangen Prozesses (oft über 8.000 bis 30.000 Jahre alt), bei dem Hunderte von verschiedenen Pflanzen – Kräuter, Blätter, Samen und Wurzeln – unter Luftabschluss durch natürliche Mikroorganismen fermentiert und umgewandelt wurden. Die entscheidenden Wirkstoffe in diesem Elixier sind nicht die Pflanzen selbst, sondern die Substanzen, die bei ihrer Zersetzung entstehen: die Huminsäuren und Fulvosäuren. Diese Huminstoffe sind es, die dem Moor seine einzigartige biochemische Kraft verleihen. Darüber hinaus enthält ein hochwertiges Moor-Elixier eine Fülle an organisch gebundenen Mineralstoffen (wie Kalzium, Magnesium, Kalium) und Spurenelementen (wie Eisen, Zink, Kupfer, Molybdän), die durch die Fermentation für den Körper hoch bioverfügbar gemacht wurden. Moor-Elixier von Waldkraft: 🛒 https://www.waldkraft.bio/moor-elixier Trinkmoor für Hunde und Katzen – Hochwertigstes Naturmoor von Waldkraft: 🛒 https://www.waldkraft.bio/phyto-moor-biologisch-aktives-vitalstofftonikum Set: 3er-Pack Trinkmoor für Hunde und Katzen – Hochwertigstes Naturmoor von Waldkraft: 🛒 https://www.waldkraft.bio/set-3er-pack-phyto-moor-3x-500ml ⸻ 🏬 Amazon Die beste Auswahl für Trinkmoor 🛒 https://amzn.to/4qqLQsd ⸻ 🌿 Waldkraft Die Kraft der Natur für Mensch & Tier Erleben Sie hochwertige Naturprodukte – von kolloidalem Silber bis Vitalpilzen. 💚 Jetzt 10 % Rabatt sichern mit dem Code: weiszpflog 👉 Direkt zum Shop 🛒 http://tinyurl.com/Waldkraft ⸻ 🎥 maona.tv Über 1.000 Filme, Vorträge & Interviews für Bewusstsein & Wandel Erleben Sie Wissen, das inspiriert. 🎬 Jetzt 14 Tage kostenlos testen 👉 Hier starten 🛒 https://tinyurl.com/tvmaona ⸻ 🎵 Gratis Meditationsalbum „Source Code“ inkl. neowake® 7 Tage Testphase Erleben Sie Klangfrequenzen für Balance & Klarheit. 👉 Jetzt sichern 🛒 https://tinyurl.com/f3yfczpp ⸻ 🔍 Metanoia Magazin Die investigative Themen-Zeitung aus der Schweiz Tauchen Sie ein in unabhängigen Journalismus, der Fragen stellt, wo andere schweigen. 👉 Jetzt entdecken 🛒 https://tinyurl.com/metanoia-magazin ⸻ 💬 Falls es Fragen gibt, beantworte ich die gerne in den Kommentaren oder auf den üblichen Kanälen: E-Mail: waldesruh@mailbox.org Webseite: https://sites.google.com/view/waldesruh-begleitung/startseite WhatsApp: https://wa.me/message/2SKXRLW4CQDHN1 Instagram: https://www.instagram.com/waldesruhbegleitung 🔎 Transparenzhinweis: Die mit „🛒“ oder entsprechenden Verweisen gekennzeichneten Links sind Affiliate-Links. Das bedeutet: Wenn Sie über einen dieser Links einkaufen, erhalte ich eine kleine Provision – ohne Mehrkosten für Sie. So unterstützen Sie meine Arbeit – z. B. den Waldesruh Ernährungspfad Podcast, Recherchen und neue Inhalte rund um gesunde Ernährung & ganzheitliches Leben. 💚 Vielen Dank für Ihre Unterstützung!Dieser Podcast wird vermarktet von der Podcastbude.www.podcastbu.de - Full-Service-Podcast-Agentur - Konzeption, Produktion, Vermarktung, Distribution und Hosting.Du möchtest deinen Podcast auch kostenlos hosten und damit Geld verdienen?Dann schaue auf www.kostenlos-hosten.de und informiere dich.Dort erhältst du alle Informationen zu unseren kostenlosen Podcast-Hosting-Angeboten. kostenlos-hosten.de ist ein Produkt der Podcastbude. (00:00) Einführung: Das schwarze Gold (00:44) Was ist Moor? Die Entstehung (02:35) Die Hauptwirkstoffe: Huminstoffe (05:05) Weitere Inhaltsstoffe: Mineralien & Synergie (06:49) Die 4 Wirkmechanismen im Detail (13:17) Warum Moor-Elixier supplementieren? (16:26) Für wen ist Moor-Elixier geeignet? (Zielgruppen) (17:33) WICHTIG: Sicherheitshinweise & Kontraindikationen (20:53) Qualität, Anwendung und Dosierung (23:16) Fazit und Zusammenfassung

Vitamin D – Mehr als nur ein Vitamin, ein essentielles Hormon
Vitamin D nimmt eine Sonderstellung unter den Vitaminen ein. Während die meisten Vitamine über die Nahrung aufgenommen werden müssen, kann unser Körper Vitamin D selbst herstellen. Alles, was er dazu braucht, ist direkte Sonneneinstrahlung auf die Haut. Genauer gesagt, die UV-B-Strahlung der Sonne. Diese wandelt eine Vorstufe in der Haut in Vitamin D3 (Cholecalciferol) um, welches dann in Leber und Nieren in seine aktive Hormonform (Calcitriol) umgewandelt wird. Seine bekannteste und unbestrittene Funktion ist die Regulation des Kalzium- und Phosphatstoffwechsels. Es sorgt dafür, dass ausreichend Kalzium aus dem Darm aufgenommen und in die Knochen eingebaut wird. Ohne Vitamin D bleiben unsere Knochen weich und brüchig. Weitere Informationen gibt es unter: https://www.youtube.com/@Waldesruh-Begleitung/posts Vitamin D3 & K2 Tropfen von Waldkraft: 🛒 https://www.waldkraft.bio/vitamin-d3-2.000-ie-k2-40-mcg-hochdosiert-30ml?sPartner=weiszpflog Vitamin K2 Tropfen von Waldkraft: 🛒 https://www.waldkraft.bio/vitamin-k2-200-mcg-30ml?sPartner=weiszpflog ⸻ 🏬 Amazon Die beste Auswahl für Vitamin D Supplemente Tabletten 🛒 https://amzn.to/46YFgS0 Tropfen 🛒 https://amzn.to/4o0r9le ⸻ 🌿 Waldkraft Die Kraft der Natur für Mensch & Tier Erleben Sie hochwertige Naturprodukte – von kolloidalem Silber bis Vitalpilzen. 💚 Jetzt 10 % Rabatt sichern mit dem Code: weiszpflog 👉 Direkt zum Shop 🛒 http://tinyurl.com/Waldkraft ⸻ 🎥 maona.tv Über 1.000 Filme, Vorträge & Interviews für Bewusstsein & Wandel Erleben Sie Wissen, das inspiriert. 🎬 Jetzt 14 Tage kostenlos testen 👉 Hier starten 🛒 https://tinyurl.com/tvmaona ⸻ 🎵 Gratis Meditationsalbum „Source Code“ inkl. neowake® 7 Tage Testphase Erleben Sie Klangfrequenzen für Balance & Klarheit. 👉 Jetzt sichern 🛒 https://tinyurl.com/f3yfczpp ⸻ 🔍 Metanoia Magazin Die investigative Themen-Zeitung aus der Schweiz Tauchen Sie ein in unabhängigen Journalismus, der Fragen stellt, wo andere schweigen. 👉 Jetzt entdecken 🛒 https://tinyurl.com/metanoia-magazin ⸻ 💬 Falls es Fragen gibt, beantworte ich die gerne in den Kommentaren oder auf den üblichen Kanälen: E-Mail: waldesruh@mailbox.org Webseite: https://sites.google.com/view/waldesruh-begleitung/startseite WhatsApp: https://wa.me/message/2SKXRLW4CQDHN1 Instagram: https://www.instagram.com/waldesruhbegleitung/ 🔎 Transparenzhinweis: Die mit „🛒“ oder entsprechenden Verweisen gekennzeichneten Links sind Affiliate-Links. Das bedeutet: Wenn Sie über einen dieser Links einkaufen, erhalte ich eine kleine Provision – ohne Mehrkosten für Sie. So unterstützen Sie meine Arbeit – z. B. den Waldesruh Ernährungspfad Podcast, Recherchen und neue Inhalte rund um gesunde Ernährung & ganzheitliches Leben. 💚 Vielen Dank für Ihre Unterstützung!Dieser Podcast wird vermarktet von der Podcastbude.www.podcastbu.de - Full-Service-Podcast-Agentur - Konzeption, Produktion, Vermarktung, Distribution und Hosting.Du möchtest deinen Podcast auch kostenlos hosten und damit Geld verdienen?Dann schaue auf www.kostenlos-hosten.de und informiere dich.Dort erhältst du alle Informationen zu unseren kostenlosen Podcast-Hosting-Angeboten. kostenlos-hosten.de ist ein Produkt der Podcastbude. (00:00) Einleitung: Das Sonnenvitamin unter der Lupe (1:13) Was ist Vitamin D? Vom Prohormon zum aktiven Schlüsselhormon (04:10) Die Aufgaben im Körper: Mehr als nur ein Knochenvitamin (07:01) Das "Vitamin-D-Mangelland" Deutschland: Ursachen & Risikofaktoren (10:31) Den Bedarf decken: Sonne, Ernährung & vegane Supplemente (14:44) Die wichtigen Partner: Warum Vitamin D K2 und Magnesium braucht (16:01) Die richtige Dosis: Messung, Empfehlungen und Sicherheit (18:55) Fazit & Anstoß zum Nachdenken

Die Wurzel der inneren Ruhe⎜Ashwagandha
In unserer lauten und oftmals hektischen Welt sehnen sich viele Menschen nach einem Anker, nach einer Quelle der Kraft, die tief in der Weisheit unserer Vorväter und der Natur selbst verwurzelt ist. Heute möchte ich Ihnen von einer solchen Kraftquelle berichten, einer Wurzel, die uns lehrt, selbst im größten Sturm des Lebens standhaft zu bleiben: Ashwagandha, die Wurzel der inneren Ruhe. 🛒 Ashwagandha KSM-66® vegan - 120 Kapseln in gewohnter Waldkraft Qualität https://www.waldkraft.bio/ashwagandha-ksm-66-vegan-120-kapseln?sPartner=weiszpflog ⸻ 🎙️ Jetzt überall verfügbar: Waldesruh Ernährungspfad 🌿 Ihr Podcast für ganzheitliche Ernährung, naturbasierte Gesundheit und pflanzenbasierte Lebensweise – fundiert, klar und alltagsnah. 🟢 Ab sofort auf Spotify, Apple Podcasts, Amazon Music & überall, wo Sie am liebsten hören. Tauchen Sie ein – für Körper, Geist und Jahreszeiten des Lebens. ⸻ 🛒 Die beste Auswahl für Ashwagandha auf Amazon findest Du unter: https://amzn.to/4gFw0FA ⸻ 🌿 Waldkraft Die Kraft der Natur für Mensch & Tier Erleben Sie hochwertige Naturprodukte – von kolloidalem Silber bis Vitalpilzen. 💚 Jetzt 10 % Rabatt sichern mit dem Code: weiszpflog 👉 Direkt zum Shop 🛒 http://tinyurl.com/Waldkraft ⸻ 🛡 Germaniens Erbe auf Patreon Als Unterstützer erhalten Sie Zugang zu Werken, die unsere Wurzeln, Ahnen und Traditionen ehren. 👉 Mitglied werden https://patreon.com/GermaniensErbe ⸻ 🎥 maona.tv Über 1.000 Filme, Vorträge & Interviews für Bewusstsein & Wandel Erleben Sie Wissen, das inspiriert. 🎬 Jetzt 14 Tage kostenlos testen 👉 Hier starten 🛒 https://tinyurl.com/tvmaona ⸻ 🎵 Gratis Meditationsalbum „Source Code“ inkl. neowake® 7 Tage Testphase Erleben Sie Klangfrequenzen für Balance & Klarheit. 👉 Jetzt sichern 🛒 https://tinyurl.com/f3yfczpp ⸻ 🎶 Suno – Musik aus Deiner Vision Entfessle Deine Kreativität und komponiere mit KI eigene Songs. 🎤 Jetzt starten auf → suno.com https://suno.com/invite/@ai_tunes ⸻ 🔍 Metanoia Magazin Die investigative Themen-Zeitung aus der Schweiz Tauchen Sie ein in unabhängigen Journalismus, der Fragen stellt, wo andere schweigen. 👉 Jetzt entdecken 🛒 https://tinyurl.com/metanoia-magazin ⸻ 💬 Falls es Fragen gibt, beantworte ich die gerne in den Kommentaren oder auf den üblichen Kanälen: E-Mail: waldesruh@mailbox.org Webseite: https://sites.google.com/view/waldesruh-begleitung/startseite Instagram: https://www.instagram.com/waldesruhbegleitung/ X: https://x.com/Waldesruh_Falco 🔎 Transparenzhinweis: Die mit „🛒“ oder entsprechenden Verweisen gekennzeichneten Links sind Affiliate-Links. Das bedeutet: Wenn Sie über einen dieser Links einkaufen, erhalte ich eine kleine Provision – ohne Mehrkosten für Sie. So unterstützen Sie meine Arbeit – z. B. den Waldesruh Ernährungspfad Podcast, Recherchen und neue Inhalte rund um gesunde Ernährung & ganzheitliches Leben. 💚 Vielen Dank für Ihre Unterstützung!Dieser Podcast wird vermarktet von der Podcastbude.www.podcastbu.de - Full-Service-Podcast-Agentur - Konzeption, Produktion, Vermarktung, Distribution und Hosting.Du möchtest deinen Podcast auch kostenlos hosten und damit Geld verdienen?Dann schaue auf www.kostenlos-hosten.de und informiere dich.Dort erhältst du alle Informationen zu unseren kostenlosen Podcast-Hosting-Angeboten. kostenlos-hosten.de ist ein Produkt der Podcastbude. (00:00:00) Ashwagandha_im_Fokus__Stresskiller,_Schlafbeere_und_Energiequel

Das goldene Naturheilmittel mit wissenschaftlicher Kraft⎜Manuka Honig
Was ist Manuka-Honig? Manuka-Honig stammt aus den Blüten des neuseeländischen Manuka-Strauchs (Leptospermum scoparium). Im Gegensatz zu herkömmlichem Honig enthält er eine einzigartige Substanz namens Methylglyoxal (MGO) – verantwortlich für seine stark antibakterielle und heilungsfördernde Wirkung. 🔍 MGO-Wert = Maß für die antibakterielle Aktivität Ein Honig mit MGO 840 enthält 840 mg Methylglyoxal pro Kilogramm – das ist ein hochkonzentrierter medizinischer Manuka-Honig, der therapeutisch wirksam ist. 🛒 Manuka Honig MGO 840 - 250g in gewohnter Waldkraft Qualität https://www.waldkraft.bio/manuka-honig-mgo-840-250g?sPartner=weiszpflog ⸻ 🎙️ Jetzt überall verfügbar: Waldesruh Ernährungspfad 🌿 Ihr Podcast für ganzheitliche Ernährung, naturbasierte Gesundheit und pflanzenbasierte Lebensweise – fundiert, klar und alltagsnah. 🟢 Ab sofort auf Spotify, Apple Podcasts, Amazon Music & überall, wo Sie am liebsten hören. Tauchen Sie ein – für Körper, Geist und Jahreszeiten des Lebens. ⸻ 🛒 Die beste Auswahl für Manuka-Honig auf Amazon findest Du unter: https://amzn.to/4nCTmhu ⸻ 🌿 Waldkraft Die Kraft der Natur für Mensch & Tier Erleben Sie hochwertige Naturprodukte – von kolloidalem Silber bis Vitalpilzen. 💚 Jetzt 10 % Rabatt sichern mit dem Code: weiszpflog 👉 Direkt zum Shop 🛒 http://tinyurl.com/Waldkraft ⸻ 🛡 Germaniens Erbe auf Patreon Als Unterstützer erhalten Sie Zugang zu Werken, die unsere Wurzeln, Ahnen und Traditionen ehren. 👉 Mitglied werden https://patreon.com/GermaniensErbe ⸻ 🎥 maona.tv Über 1.000 Filme, Vorträge & Interviews für Bewusstsein & Wandel Erleben Sie Wissen, das inspiriert. 🎬 Jetzt 14 Tage kostenlos testen 👉 Hier starten 🛒 https://tinyurl.com/tvmaona ⸻ 🎵 Gratis Meditationsalbum „Source Code“ inkl. neowake® 7 Tage Testphase Erleben Sie Klangfrequenzen für Balance & Klarheit. 👉 Jetzt sichern 🛒 https://tinyurl.com/f3yfczpp ⸻ 🎶 Suno – Musik aus Deiner Vision Entfessle Deine Kreativität und komponiere mit KI eigene Songs. 🎤 Jetzt starten auf → suno.com https://suno.com/invite/@ai_tunes ⸻ 🔍 Metanoia Magazin Die investigative Themen-Zeitung aus der Schweiz Tauchen Sie ein in unabhängigen Journalismus, der Fragen stellt, wo andere schweigen. 👉 Jetzt entdecken 🛒 https://tinyurl.com/metanoia-magazin ⸻ 💬 Falls es Fragen gibt, beantworte ich die gerne in den Kommentaren oder auf den üblichen Kanälen: E-Mail: waldesruh@mailbox.org Webseite: https://sites.google.com/view/waldesruh-begleitung/startseite Instagram: https://www.instagram.com/waldesruhbegleitung/ X: https://x.com/Waldesruh_Falco 🔎 Transparenzhinweis: Die mit „🛒“ oder entsprechenden Verweisen gekennzeichneten Links sind Affiliate-Links. Das bedeutet: Wenn Sie über einen dieser Links einkaufen, erhalte ich eine kleine Provision – ohne Mehrkosten für Sie. So unterstützen Sie meine Arbeit – z. B. den Waldesruh Ernährungspfad Podcast, Recherchen und neue Inhalte rund um gesunde Ernährung & ganzheitliches Leben. 💚 Vielen Dank für Ihre Unterstützung!Dieser Podcast wird vermarktet von der Podcastbude.www.podcastbu.de - Full-Service-Podcast-Agentur - Konzeption, Produktion, Vermarktung, Distribution und Hosting.Du möchtest deinen Podcast auch kostenlos hosten und damit Geld verdienen?Dann schaue auf www.kostenlos-hosten.de und informiere dich.Dort erhältst du alle Informationen zu unseren kostenlosen Podcast-Hosting-Angeboten. kostenlos-hosten.de ist ein Produkt der Podcastbude. (00:00:00) Manuka Honig - MGO 840 Flüssiges Gold aus Neuseeland

Besser als Ibuprofen⎜PEA
PEA ist keine schnelle Pille, sondern ein stetiger Unterstützer. Es hilft deinem Körper, Entzündungen zu regulieren, Nervensystem und Immunsystem ins Gleichgewicht zu bringen – und das ganz natürlich, ohne Nebenwirkungen. 🌿 Ob du unter Schmerzen leidest, sensibel auf Stress reagierst oder dein Nervensystem ganzheitlich stärken willst – PEA ist eine moderne Antwort auf stille Entzündungen und Überlastung. PEA - Palmitoylethanolamid Pulver - 36g 🛒 https://www.waldkraft.bio/pea-palmitoylethanolamid-pulver-36g?sPartner=weiszpflog PEA - Palmitoylethanolamid Drops 🛒 https://www.waldkraft.bio/pea-palmitoylethanolamid-drops?sPartner=weiszpflog PEA - Palmitoylethanolamid - 120 Kapseln (400mg) 🛒 https://www.waldkraft.bio/pea-palmitoylethanolamid-120-kapseln-400mg?sPartner=weiszpflog Set: 3er Pack - PEA - 3x 120 Kapseln 🛒 https://www.waldkraft.bio/set-3er-pack-pea-3x-120-kapseln?sPartner=weiszpflog 🛒 PEA - Palmitoylethanolamid Pulver Für Hunde und Katzen https://www.waldkraft.bio/pea-palmitoylethanolamid-pulver-fuer-hunde-und-katzen?sPartner=weiszpflog ⸻ 🎙️ Jetzt überall verfügbar: Waldesruh Ernährungspfad 🌿 Ihr Podcast für ganzheitliche Ernährung, naturbasierte Gesundheit und pflanzenbasierte Lebensweise – fundiert, klar und alltagsnah. 🟢 Ab sofort auf Spotify, Apple Podcasts, Amazon Music & überall, wo Sie am liebsten hören. Tauchen Sie ein – für Körper, Geist und Jahreszeiten des Lebens. ⸻ 🛒 Die beste Auswahl für Nahrungsergänzung auf Amazon findest Du unter folgenden Affiliate-Link: Amazon: https://amzn.to/4lcx2dS (Als Amazon-Partner verdiene ich an qualifizierten Verkäufen.) ⸻ 🌿 Waldkraft Die Kraft der Natur für Mensch & Tier Erleben Sie hochwertige Naturprodukte – von kolloidalem Silber bis Vitalpilzen. 💚 Jetzt 10 % Rabatt sichern mit dem Code: weiszpflog 👉 Direkt zum Shop 🛒 http://tinyurl.com/Waldkraft ⸻ 🛡 Germaniens Erbe auf Patreon Als Unterstützer erhalten Sie Zugang zu Werken, die unsere Wurzeln, Ahnen und Traditionen ehren. 👉 Mitglied werden https://patreon.com/GermaniensErbe ⸻ 🎥 maona.tv Über 1.000 Filme, Vorträge & Interviews für Bewusstsein & Wandel Erleben Sie Wissen, das inspiriert. 🎬 Jetzt 14 Tage kostenlos testen 👉 Hier starten 🛒 https://tinyurl.com/tvmaona ⸻ 🎵 Gratis Meditationsalbum „Source Code“ inkl. neowake® 7 Tage Testphase Erleben Sie Klangfrequenzen für Balance & Klarheit. 👉 Jetzt sichern 🛒 https://tinyurl.com/f3yfczpp ⸻ 🎶 Suno – Musik aus deiner Vision Entfessle deine Kreativität und komponiere mit KI eigene Songs. 🎤 Jetzt starten auf → suno.com https://suno.com/invite/@ai_tunes ⸻ 🔍 Metanoia Magazin Die investigative Themen-Zeitung aus der Schweiz Tauchen Sie ein in unabhängigen Journalismus, der Fragen stellt, wo andere schweigen. 👉 Jetzt entdecken 🛒 https://tinyurl.com/metanoia-magazin ⸻ 💬 Falls es Fragen gibt, beantworte ich die gerne in den Kommentaren oder auf den üblichen Kanälen: E-Mail: waldesruh@mailbox.org Webseite: https://sites.google.com/view/waldesruh-begleitung/startseite Instagram: https://www.instagram.com/waldesruhbegleitung/ 🔎 Transparenzhinweis: Die mit „🛒“ oder entsprechenden Verweisen gekennzeichneten Links sind Affiliate-Links. Das bedeutet: Wenn Sie über einen dieser Links einkaufen, erhalte ich eine kleine Provision – ohne Mehrkosten für Sie. So unterstützen Sie meine Arbeit – z. B. den Waldesruh Ernährungspfad Podcast, Recherchen und neue Inhalte rund um gesunde Ernährung & ganzheitliches Leben. 💚 Vielen Dank für Ihre Unterstützung!+++ WERBUNG +++Ghost of Yōtei - das Action-Adventure - exklusiv für PS5 ab 2. Oktober hier erhältlich:https://www.playstation.com/de-de/games/ghost-of-yotei/Dieser Podcast wird vermarktet von der Podcastbude.www.podcastbu.de - Full-Service-Podcast-Agentur - Konzeption, Produktion, Vermarktung, Distribution und Hosting.Du möchtest deinen Podcast auch kostenlos hosten und damit Geld verdienen?Dann schaue auf www.kostenlos-hosten.de und informiere dich.Dort erhältst du alle Informationen zu unseren kostenlosen Podcast-Hosting-Angeboten. kostenlos-hosten.de ist ein Produkt der Podcastbude. (00:00:00) PEA - Der körpereigene Schmerzmanager

Die natürliche Balance für dein Nervensystem⎜Safran Drops mit Vitamin B12, B6 und B5
Was macht Safran so besonders? Safran (Crocus sativus) ist viel mehr als nur ein edles Gewürz. Er enthält bioaktive Inhaltsstoffe wie Crocin, Safranal und Picrocrocin, die in Studien nachweislich positive Effekte auf das Nervensystem, die Stimmung und die Stressregulation zeigen. Safran wird seit Jahrhunderten in der traditionellen Heilkunde verwendet, etwa bei: •Niedergeschlagenheit und Stimmungstiefs •Unruhe und Stress •Schlafproblemen Kombiniert mit den B-Vitaminen B12, B6 und B5, wie es Waldkraft in seinen Drops tut, ergibt sich ein kraftvolles neuroaktives und stimmungsaufhellendes Komplettpräparat. Safran Drops von Waldkraft findest Du hier. 10% sparen mit dem Code: weiszpflog - kombinierbar mit Rabattaktionen um noch mehr zu sparen. 🎙️ Jetzt überall verfügbar: Waldesruh Ernährungspfad 🌿 Ihr Podcast für ganzheitliche Ernährung, naturbasierte Gesundheit und pflanzenbasierte Lebensweise – fundiert, klar und alltagsnah. 🟢 Ab sofort auf Spotify, Apple Podcasts, Amazon Music & überall, wo Sie am liebsten hören. Tauchen Sie ein – für Körper, Geist und Jahreszeiten des Lebens. Detaillierte Informationen und mehr findest Du HIER. ⸻ Die beste Auswahl für Nahrungsergänzung auf Amazon findest du unter folgenden Affiliate-Link: https://amzn.to/4lcx2dS (Als Amazon-Partner verdiene ich an qualifizierten Verkäufen.) ⸻ 🌿 Waldkraft Die Kraft der Natur für Mensch & Tier Erleben Sie hochwertige Naturprodukte – von kolloidalem Silber bis Vitalpilzen. 💚 Jetzt 10 % Rabatt sichern mit dem Code: weiszpflog 👉 Direkt zum Shop ⸻ 🛡 Germaniens Erbe auf Patreon Als Unterstützer erhalten Sie Zugang zu Werken, die unsere Wurzeln, Ahnen und Traditionen ehren. 👉 Mitglied werden ⸻ 🎥 maona.tv Über 1.000 Filme, Vorträge & Interviews für Bewusstsein & Wandel Erleben Sie Wissen, das inspiriert. 🎬 Jetzt 14 Tage kostenlos testen 👉 Hier starten ⸻ 🎵 Gratis Meditationsalbum „Source Code“ inkl. neowake® 7 Tage Testphase Erleben Sie Klangfrequenzen für Balance & Klarheit. 👉 Jetzt sichern ⸻ 🎶 Suno – Musik aus deiner Vision Entfessle deine Kreativität und komponiere mit KI eigene Songs. 🎤 Jetzt starten auf → suno.com ⸻ 🔍 Metanoia Magazin Die investigative Themen-Zeitung aus der Schweiz Tauchen Sie ein in unabhängigen Journalismus, der Fragen stellt, wo andere schweigen. 👉 Jetzt entdecken ⸻ 💬 Falls es Fragen gibt, beantworte ich die gerne in den Kommentaren oder auf den üblichen Kanälen: E-Mail: waldesruh@mailbox.org Webseite WhatsApp WhatsApp-Kanal+++ WERBUNG +++Ghost of Yōtei - das Action-Adventure - exklusiv für PS5 ab 2. Oktober hier erhältlich:https://www.playstation.com/de-de/games/ghost-of-yotei/Dieser Podcast wird vermarktet von der Podcastbude.www.podcastbu.de - Full-Service-Podcast-Agentur - Konzeption, Produktion, Vermarktung, Distribution und Hosting.Du möchtest deinen Podcast auch kostenlos hosten und damit Geld verdienen?Dann schaue auf www.kostenlos-hosten.de und informiere dich.Dort erhältst du alle Informationen zu unseren kostenlosen Podcast-Hosting-Angeboten. kostenlos-hosten.de ist ein Produkt der Podcastbude. (00:00) Kapitel 1

Pflanzliche Power für deine Gesundheit ⎜ Eiweißsupplemente
Was sind vegane Eiweiß-Supplemente? Vegane Eiweiß-Supplemente sind Proteinpulver oder Tabletten auf pflanzlicher Basis, die zur Deckung des Eiweißbedarfs beitragen. Sie bestehen meist aus: - Erbsenprotein - Reisprotein - Hanfeiweiß - Kürbiskernprotein - Sonnenblumenkern- oder - Lupinenprotein Oft werden mehrere Proteinquellen kombiniert, um ein komplettes Aminosäureprofil zu erreichen. Für Bio-Qualität werden die Pflanzen schonend verarbeitet, ohne künstliche Zusatzstoffe. 🎙️ Jetzt überall verfügbar: Waldesruh Ernährungspfad 🌿 Ihr Podcast für ganzheitliche Ernährung, naturbasierte Gesundheit und pflanzenbasierte Lebensweise – fundiert, klar und alltagsnah. 🟢 Ab sofort auf Spotify, Apple Podcasts, Amazon Music & überall, wo Sie am liebsten hören. Tauchen Sie ein – für Körper, Geist und Jahreszeiten des Lebens. Detaillierte Informationen und mehr findest Du HIER. ⸻ Meine persönlichen Favoriten sind: Vegan Protein – SALTED CARAMEL Vegan Protein – BANANE Vegan Protein – HASELNUSS Vegan Protein – ERDNUSSBUTTER Affiliate-Link zu Amazon: (Als Amazon-Partner verdiene ich an qualifizierten Verkäufen.) ⸻ 🌿 Waldkraft Die Kraft der Natur für Mensch & Tier Erleben Sie hochwertige Naturprodukte – von kolloidalem Silber bis Vitalpilzen. 💚 Jetzt 10 % Rabatt sichern mit dem Code: weiszpflog 👉 Direkt zum Shop ⸻ 🛡 Germaniens Erbe auf Patreon Als Unterstützer erhalten Sie Zugang zu Werken, die unsere Wurzeln, Ahnen und Traditionen ehren. 👉 Mitglied werden ⸻ 🎥 maona.tv Über 1.000 Filme, Vorträge & Interviews für Bewusstsein & Wandel Erleben Sie Wissen, das inspiriert. 🎬 Jetzt 14 Tage kostenlos testen 👉 Hier starten ⸻ 🎵 Gratis Meditationsalbum „Source Code“ inkl. neowake® 7 Tage Testphase Erleben Sie Klangfrequenzen für Balance & Klarheit. 👉 Jetzt sichern ⸻ 🎶 Suno – Musik aus deiner Vision Entfessle deine Kreativität und komponiere mit KI eigene Songs. 🎤 Jetzt starten auf → suno.com ⸻ 🔍 Metanoia Magazin Die investigative Themen-Zeitung aus der Schweiz Tauchen Sie ein in unabhängigen Journalismus, der Fragen stellt, wo andere schweigen. 👉 Jetzt entdecken ⸻ 💬 Falls es Fragen gibt, beantworte ich die gerne in den Kommentaren oder auf den üblichen Kanälen: E-Mail: waldesruh@mailbox.org Webseite WhatsApp-Kanal+++ WERBUNG +++Ghost of Yōtei - das Action-Adventure - exklusiv für PS5 ab 2. Oktober hier erhältlich:https://www.playstation.com/de-de/games/ghost-of-yotei/Dieser Podcast wird vermarktet von der Podcastbude.www.podcastbu.de - Full-Service-Podcast-Agentur - Konzeption, Produktion, Vermarktung, Distribution und Hosting.Du möchtest deinen Podcast auch kostenlos hosten und damit Geld verdienen?Dann schaue auf www.kostenlos-hosten.de und informiere dich.Dort erhältst du alle Informationen zu unseren kostenlosen Podcast-Hosting-Angeboten. kostenlos-hosten.de ist ein Produkt der Podcastbude. (00:00) Profuel V-PROTEIN 4K_ Veganer Protein-Leitfaden

Die grüne Kraft für deinen Körper ⎜ BIO Spirulina
Was ist Spirulina? Spirulina ist eine blaugrüne Mikroalge, genauer gesagt eine cyanobakterielle Lebensform, die seit über 3,5 Milliarden Jahren existiert. Sie wächst in alkalischen Süßwasserseen – traditionell in Regionen wie Mexiko, Afrika oder Asien. Heute wird sie in speziellen Bio-Kulturen unter kontrollierten Bedingungen kultiviert. Spirulina ist reich an lebenswichtigen Mikronährstoffen, Proteinen, sekundären Pflanzenstoffen und Chlorophyll. Sie zählt zu den nährstoffreichsten Lebensmitteln der Welt und ist ein echtes Superfood für Körper, Geist und Immunsystem. 🎙️ Jetzt überall verfügbar: Waldesruh Ernährungspfad 🌿 Ihr Podcast für ganzheitliche Ernährung, naturbasierte Gesundheit und pflanzenbasierte Lebensweise – fundiert, klar und alltagsnah. 🟢 Ab sofort auf Spotify, Apple Podcasts, Amazon Music & überall, wo Sie am liebsten hören. Tauchen Sie ein – für Körper, Geist und Jahreszeiten des Lebens. Detaillierte Informationen und mehr findest Du hier. BIO Spirulina – Die grüne Kraft für Ihren Körper 🌿 Mit wertvollen Mikronährstoffen, Chlorophyll und hochwertigem pflanzlichem Eiweiß ist Spirulina ein wahres Naturkraftpaket. ✅ 100 % bio-zertifiziert ✅ Schonend verarbeitet ✅ Von Waldkraft in geprüfter Premium-Qualität 💚 Für Energie, Zellschutz & Vitalität – jeden Tag. 👉 Jetzt entdecken in Form von: BIO Spirulina Pulver BIO Spirulina Kapseln BIO Spirulina Presslinge 💚 Jetzt 10 % Rabatt sichern mit dem Code: weiszpflog 🌿 Waldkraft Die Kraft der Natur für Mensch & Tier Erleben Sie hochwertige Naturprodukte – von kolloidalem Silber bis Vitalpilzen. 💚 Jetzt 10 % Rabatt sichern mit dem Code: weiszpflog 👉 Direkt zum Shop Affiliate-Link zu Amazon. (Als Amazon-Partner verdiene ich an qualifizierten Verkäufen.) 🎥 maona.tv Über 1.000 Filme, Vorträge & Interviews für Bewusstsein & Wandel Erleben Sie Wissen, das inspiriert. 🎬 Jetzt 14 Tage kostenlos testen 👉 Hier starten 🎵 Gratis Meditationsalbum „Source Code“ inkl. neowake® 7 Tage Testphase Erleben Sie Klangfrequenzen für Balance & Klarheit. 👉 Jetzt sichern 🛡 Germaniens Erbe auf Patreon Als Unterstützer erhalten Sie Zugang zu Werken, die unsere Wurzeln, Ahnen und Traditionen ehren. 👉 Mitglied werden+++ WERBUNG +++Ghost of Yōtei - das Action-Adventure - exklusiv für PS5 ab 2. Oktober hier erhältlich:https://www.playstation.com/de-de/games/ghost-of-yotei/Dieser Podcast wird vermarktet von der Podcastbude.www.podcastbu.de - Full-Service-Podcast-Agentur - Konzeption, Produktion, Vermarktung, Distribution und Hosting.Du möchtest deinen Podcast auch kostenlos hosten und damit Geld verdienen?Dann schaue auf www.kostenlos-hosten.de und informiere dich.Dort erhältst du alle Informationen zu unseren kostenlosen Podcast-Hosting-Angeboten. kostenlos-hosten.de ist ein Produkt der Podcastbude. (00:00) Kapitel 1

Naturmineral mit 80% Klinoptilolith ⎜ Zeolith
Was ist Zeolith? Zeolith ist ein natürlich vorkommendes, mikroporöses Vulkangestein mit einer einzigartigen Kristallstruktur. Es entsteht, wenn vulkanische Asche mit Meerwasser oder Süßwasser reagiert – ein Prozess, der über Jahrtausende stattfindet. Das Besondere an Zeolith ist seine Fähigkeit, Schadstoffe wie ein Schwamm zu binden und aus dem Körper auszuleiten. Dafür verantwortlich ist seine hohe Kationenaustausch-Kapazität und seine große innere Oberfläche. Am bekanntesten in der Gesundheitsanwendung ist der klinoptilolithhaltige Zeolith – er wird speziell gereinigt und mikronisiert, um eine sichere Anwendung als Nahrungsergänzungsmittel zu gewährleisten. Detaillierte Informationen und mehr finden Sie hier. Qualitativ hochwertiges Zeolith bei Waldkraft kaufen. Zeolith - Naturmineral mit 80% Klinoptilolith: 🌿 Waldkraft Die Kraft der Natur für Mensch & Tier Erleben Sie hochwertige Naturprodukte – von kolloidalem Silber bis Vitalpilzen. 💚 Jetzt 10 % Rabatt sichern mit dem Code: weiszpflog 👉 Direkt zum Shop 🎥 maona.tv Über 1.000 Filme, Vorträge & Interviews für Bewusstsein & Wandel Erleben Sie Wissen, das inspiriert. 🎬 Jetzt 14 Tage kostenlos testen 👉 Hier starten 🎵 Gratis Meditationsalbum „Source Code“ inkl. neowake® 7 Tage Testphase Erleben Sie Klangfrequenzen für Balance & Klarheit. 👉 Jetzt sichern 🛡 Germaniens Erbe auf Patreon Als Unterstützer erhalten Sie Zugang zu Werken, die unsere Wurzeln, Ahnen und Traditionen ehren. 👉 Mitglied werden+++ WERBUNG +++Ghost of Yōtei - das Action-Adventure - exklusiv für PS5 ab 2. Oktober hier erhältlich:https://www.playstation.com/de-de/games/ghost-of-yotei/Dieser Podcast wird vermarktet von der Podcastbude.www.podcastbu.de - Full-Service-Podcast-Agentur - Konzeption, Produktion, Vermarktung, Distribution und Hosting.Du möchtest deinen Podcast auch kostenlos hosten und damit Geld verdienen?Dann schaue auf www.kostenlos-hosten.de und informiere dich.Dort erhältst du alle Informationen zu unseren kostenlosen Podcast-Hosting-Angeboten. kostenlos-hosten.de ist ein Produkt der Podcastbude. (00:00) Kapitel 1

Der natürliche Booster für Entgiftung, Lunge & Immunsystem ⎜ NAC (N-Acetyl-L-Cystein)
Was ist NAC? N-Acetyl-L-Cystein – kurz NAC – ist die stabile, gut bioverfügbare Form der Aminosäure Cystein. Cystein ist wiederum eine schwefelhaltige Aminosäure, die unser Körper für zahlreiche lebenswichtige Prozesse benötigt. Besonders bedeutend ist NAC als Vorstufe von Glutathion – unserem wichtigsten körpereigenen Antioxidans und Entgiftungsmolekül. Glutathion schützt unsere Zellen, entgiftet Schwermetalle und oxidierte Fette und sorgt dafür, dass wir vital und widerstandsfähig bleiben. NAC wird seit Jahrzehnten auch in der medizinischen Therapie eingesetzt – z. B. zur Leberentgiftung, als Schleimlöser bei Lungenkrankheiten und als Schutzfaktor bei oxidativem Stress. Mehr über NAC erfährst du hier. 🌿 Waldkraft Die Kraft der Natur für Mensch & Tier Erleben Sie hochwertige Naturprodukte – von kolloidalem Silber bis Vitalpilzen. NAC in Kapseln findest du hier. NAC als Pulver zum Selbstdosieren gibt es hier. 💚 Jetzt 10 % Rabatt sichern mit dem Code: weiszpflog 👉 Direkt zum Shop+++ WERBUNG +++Ghost of Yōtei - das Action-Adventure - exklusiv für PS5 ab 2. Oktober hier erhältlich:https://www.playstation.com/de-de/games/ghost-of-yotei/Dieser Podcast wird vermarktet von der Podcastbude.www.podcastbu.de - Full-Service-Podcast-Agentur - Konzeption, Produktion, Vermarktung, Distribution und Hosting.Du möchtest deinen Podcast auch kostenlos hosten und damit Geld verdienen?Dann schaue auf www.kostenlos-hosten.de und informiere dich.Dort erhältst du alle Informationen zu unseren kostenlosen Podcast-Hosting-Angeboten. kostenlos-hosten.de ist ein Produkt der Podcastbude. (00:00) Kapitel 1

Atemhilfe aus der Natur ⎜ Echtes Lungenkraut (Pulmonaria officinalis)
Was ist Lungenkraut? Das echte Lungenkraut, botanisch Pulmonaria officinalis, ist eine mehrjährige Heilpflanze aus der Familie der Raublattgewächse. Sie ist in Europa weit verbreitet und wächst bevorzugt an schattigen, feuchten Standorten in Laubwäldern. Die Pflanze wird wegen ihrer charakteristischen gefleckten Blätter auch als „Lungwort“ bezeichnet – ein Hinweis auf ihre traditionelle Anwendung bei Lungenerkrankungen. Lungenkraut wird seit dem Mittelalter in der Pflanzenheilkunde verwendet. Die Signaturenlehre glaubte, dass die blattähnliche Struktur an eine Lunge erinnert – ein „Zeichen“ für seine Wirksamkeit bei Atemwegserkrankungen. Heute bestätigen moderne Analysen, dass Lungenkraut reich an gesundheitsfördernden Wirkstoffen ist. Detaillierte Informationen und mehr finden Sie hier. Qualitativ hochwertiges Lungenkraut Komplex bei Waldkraft kaufen. Lungenkraut Komplex im 3er-Set zum Vorteilspreis. 🌿 Waldkraft Die Kraft der Natur für Mensch & Tier Erleben Sie hochwertige Naturprodukte – von kolloidalem Silber bis Vitalpilzen. 💚 Jetzt 10 % Rabatt sichern mit dem Code: weiszpflog 👉 Direkt zum Shop 🎥 maona.tv Über 1.000 Filme, Vorträge & Interviews für Bewusstsein & Wandel Erleben Sie Wissen, das inspiriert. 🎬 Jetzt 14 Tage kostenlos testen 👉 Hier starten 🎵 Gratis Meditationsalbum „Source Code“ inkl. neowake® 7 Tage Testphase Erleben Sie Klangfrequenzen für Balance & Klarheit. 👉 Jetzt sichern 🛡 Germaniens Erbe auf Patreon Als Unterstützer erhalten Sie Zugang zu Werken, die unsere Wurzeln, Ahnen und Traditionen ehren. 👉 Mitglied werden+++ WERBUNG +++Ghost of Yōtei - das Action-Adventure - exklusiv für PS5 ab 2. Oktober hier erhältlich:https://www.playstation.com/de-de/games/ghost-of-yotei/Dieser Podcast wird vermarktet von der Podcastbude.www.podcastbu.de - Full-Service-Podcast-Agentur - Konzeption, Produktion, Vermarktung, Distribution und Hosting.Du möchtest deinen Podcast auch kostenlos hosten und damit Geld verdienen?Dann schaue auf www.kostenlos-hosten.de und informiere dich.Dort erhältst du alle Informationen zu unseren kostenlosen Podcast-Hosting-Angeboten. kostenlos-hosten.de ist ein Produkt der Podcastbude. (00:00) Kapitel 1

MSM – Warum es deiner Gesundheit guttut
MSM ist ein vielseitiger Gesundheits-Booster mit entzündungshemmender, regenerierender und entgiftender Wirkung. Ob für bewegliche Gelenke, schöne Haut und Haare, ein starkes Immunsystem oder zur natürlichen Entgiftung – MSM ist eine smarte, wissenschaftlich fundierte Ergänzung für jeden gesundheitsbewussten Menschen. Detaillierte Informationen und mehr finden Sie hier. Qualitativ hochwertiges MSM bei Waldkraft kaufen: MSM - Kapseln Borax + MSM - Kapseln 🌿 Waldkraft Die Kraft der Natur für Mensch & Tier Erleben Sie hochwertige Naturprodukte – von kolloidalem Silber bis Vitalpilzen. 💚 Jetzt 10 % Rabatt sichern mit dem Code: weiszpflog 👉 Direkt zum Shop 🎥 maona.tv Über 1.000 Filme, Vorträge & Interviews für Bewusstsein & Wandel Erleben Sie Wissen, das inspiriert. 🎬 Jetzt 14 Tage kostenlos testen 👉 Hier starten 🎵 Gratis Meditationsalbum „Source Code“ inkl. neowake® 7 Tage Testphase Erleben Sie Klangfrequenzen für Balance & Klarheit. 👉 Jetzt sichern 🛡 Germaniens Erbe auf Patreon Als Unterstützer erhalten Sie Zugang zu Werken, die unsere Wurzeln, Ahnen und Traditionen ehren. 👉 Mitglied werden+++ WERBUNG +++Ghost of Yōtei - das Action-Adventure - exklusiv für PS5 ab 2. Oktober hier erhältlich:https://www.playstation.com/de-de/games/ghost-of-yotei/Dieser Podcast wird vermarktet von der Podcastbude.www.podcastbu.de - Full-Service-Podcast-Agentur - Konzeption, Produktion, Vermarktung, Distribution und Hosting.Du möchtest deinen Podcast auch kostenlos hosten und damit Geld verdienen?Dann schaue auf www.kostenlos-hosten.de und informiere dich.Dort erhältst du alle Informationen zu unseren kostenlosen Podcast-Hosting-Angeboten. kostenlos-hosten.de ist ein Produkt der Podcastbude. (00:00) Kapitel 1

Ein Spurenelement rettet dein Leben – und du hast es garantiert unterschätzt!⎜Selen
Selen – Ein unterschätztes Spurenelement mit großer Wirkung Selen ist ein essentielles Spurenelement, das der Körper nicht selbst herstellen kann. Es muss über die Ernährung oder Nahrungsergänzung aufgenommen werden. Obwohl der Tagesbedarf gering ist (etwa 55–70 µg pro Tag), ist Selen an zahlreichen lebenswichtigen Prozessen beteiligt – von der Immunabwehr über die Schilddrüsenfunktion bis zum Zellschutz. Detaillierte Informationen finden Sie hier. Qualitativ hochwertiges Selen mit Vitamin C bei Waldkraft kaufen. 🌿 Waldkraft Die Kraft der Natur für Mensch & Tier Erleben Sie hochwertige Naturprodukte – von kolloidalem Silber bis Vitalpilzen. 💚 Jetzt 10 % Rabatt sichern mit dem Code: weiszpflog 👉 Direkt zum Shop 🎥 maona.tv Über 1.000 Filme, Vorträge & Interviews für Bewusstsein & Wandel Erleben Sie Wissen, das inspiriert. 🎬 Jetzt 14 Tage kostenlos testen 👉 Hier starten 🎵 Gratis Meditationsalbum „Source Code“ inkl. neowake® 7 Tage Testphase Erleben Sie Klangfrequenzen für Balance & Klarheit. 👉 Jetzt sichern 🛡 Germaniens Erbe auf Patreon Als Unterstützer erhalten Sie Zugang zu Werken, die unsere Wurzeln, Ahnen und Traditionen ehren. 👉 Mitglied werden+++ WERBUNG +++Ghost of Yōtei - das Action-Adventure - exklusiv für PS5 ab 2. Oktober hier erhältlich:https://www.playstation.com/de-de/games/ghost-of-yotei/Dieser Podcast wird vermarktet von der Podcastbude.www.podcastbu.de - Full-Service-Podcast-Agentur - Konzeption, Produktion, Vermarktung, Distribution und Hosting.Du möchtest deinen Podcast auch kostenlos hosten und damit Geld verdienen?Dann schaue auf www.kostenlos-hosten.de und informiere dich.Dort erhältst du alle Informationen zu unseren kostenlosen Podcast-Hosting-Angeboten. kostenlos-hosten.de ist ein Produkt der Podcastbude. (00:00) Kapitel 1

99 % der Menschen kennen OPC (Oligomere Proanthocyanidine) nicht
Was ist OPC? OPC (Oligomere Proanthocyanidine) sind sekundäre Pflanzenstoffe aus der Gruppe der Polyphenole. Besonders reichhaltig kommen sie in Traubenkernen, der Rinde der französischen Meereskiefer und in bestimmten Beerenarten vor. OPC wird als eines der stärksten bekannten natürlichen Antioxidantien geschätzt – sogar wirksamer als Vitamin C oder E. OPC ist sowohl wasser- als auch fettlöslich und kann daher nahezu alle Zellen im Körper erreichen. Es schützt, regeneriert und unterstützt das Immunsystem sowie zahlreiche Körperfunktionen – ein wahrer Alleskönner für deine Gesundheit. Detaillierte Informationen zu OPC. Qualitatives OPC bei Waldkraft kaufen. 🌿 Waldkraft Die Kraft der Natur für Mensch & Tier Erleben Sie hochwertige Naturprodukte – von kolloidalem Silber bis Vitalpilzen. 💚 Jetzt 10 % Rabatt sichern mit dem Code: weiszpflog 👉 Direkt zum Shop 🎥 maona.tv Über 1.000 Filme, Vorträge & Interviews für Bewusstsein & Wandel Erleben Sie Wissen, das inspiriert. 🎬 Jetzt 14 Tage kostenlos testen 👉 Hier starten 🎵 Gratis Meditationsalbum „Source Code“ inkl. neowake® 7 Tage Testphase Erleben Sie Klangfrequenzen für Balance & Klarheit. 👉 Jetzt sichern 🛡 Germaniens Erbe auf Patreon Als Unterstützer erhalten Sie Zugang zu Werken, die unsere Wurzeln, Ahnen und Traditionen ehren. 👉 Mitglied werden+++ WERBUNG +++Ghost of Yōtei - das Action-Adventure - exklusiv für PS5 ab 2. Oktober hier erhältlich:https://www.playstation.com/de-de/games/ghost-of-yotei/Dieser Podcast wird vermarktet von der Podcastbude.www.podcastbu.de - Full-Service-Podcast-Agentur - Konzeption, Produktion, Vermarktung, Distribution und Hosting.Du möchtest deinen Podcast auch kostenlos hosten und damit Geld verdienen?Dann schaue auf www.kostenlos-hosten.de und informiere dich.Dort erhältst du alle Informationen zu unseren kostenlosen Podcast-Hosting-Angeboten. kostenlos-hosten.de ist ein Produkt der Podcastbude. (00:00) Kapitel 1
